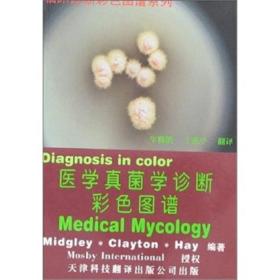

Practical Clinical Microbiology and Mycology:Techniques and Interpretations实用临床细菌学和真菌学:技术和解释(英文版)
¥128.00 85
鼎鼎经籍铺 2024-11-21

Practical Clinical Microbiology and Mycology:Techniques and Interpretations实用临床细菌学和真菌学:技术和解释(英文版)
¥135.00 85
诗文卓越书店 2024-11-13

Review of Medical Microbiology and Immunology 15E 英文原版 医学微生物学和免疫学综述 传染病 临床应用指导 细菌学,病毒学,真菌学,寄生虫学
¥500.00 95
北京书香外文 2023-12-07

预订Review of Medical Microbiology and Immunology 17E 英文原版 医学微生物学和免疫学综述 传染病 临床应用指导 细菌学,病毒学,真菌学,寄生虫学
¥599.00 95
北京书香外文 2020-11-01